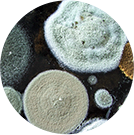

Allergia alla polvere e agli acari
Anche se non li vediamo, gli acari della polvere vivono in mezzo a noi. Questi insetti microscopici simili a ragni si nascondono in ogni angolo della casa: si attaccano ai tessuti, alla tappezzeria, alla biancheria da letto, ai cuscini e ai materassi. Gli acari della polvere sono la causa principale delle allergie domestiche.
Questi insetti, invisibili a occhio nudo, vivono solo negli ambienti interni e si nutrono dei milioni di cellule morte eliminate ogni giorno dallo strato cutaneo dell'organismo umano. La polvere domestica è costituita da diverse particelle: fibre di tessuto, batteri e acari della polvere.
Come per tutti gli altri fattori scatenanti, prima di elaborare delle strategie di gestione su misura occorre accertarsi che i sintomi siano effettivamente causati dagli acari.
La rinite allergica causata da muffe
Sebbene i sintomi della rinite allergica siano generalmente associati alle piante e ai pollini, le spore rilasciate dalle muffe rappresentano spesso un nemico occulto, capace di provocare sintomi simili a quelli dell'allergia ai pollini. Le muffe sono un allergene comune presente in natura negli ambienti esterni, ma possono anche attecchire in luoghi umidi dentro le mura domestiche. La crescita delle muffe raggiunge il picco alla fine dell'estate e, a seconda dell'umidità della zona, può continuare fino all'autunno.
Le muffe rilasciano minuscole spore in sospensione capaci di provocare reazioni allergiche; tali spore si trovano sia all'aperto che al chiuso e possono crescere in qualsiasi luogo che presenti condizioni favorevoli (luoghi umidi e oscuri). Riconoscere un'allergia alle muffe è il primo passo per una gestione adeguata. Il problema può essere risolto completamente eliminando la fonte della muffa.
Clicca qui per saperne di più su come gestire le allergie. In alternativa, clicca qui per ricevere ulteriori consigli sulla gestione delle allergie domestiche.

I principi attivi
Scopri i vari principi attivi che aiutano a combattere le allergie e trova quello più adatto a te.

Vuoi combattere l'allergia?
Puoi scoprire un trattamento antiallergico con le compresse di Reactine, a base di cetirizina e pseudoefedrina.

